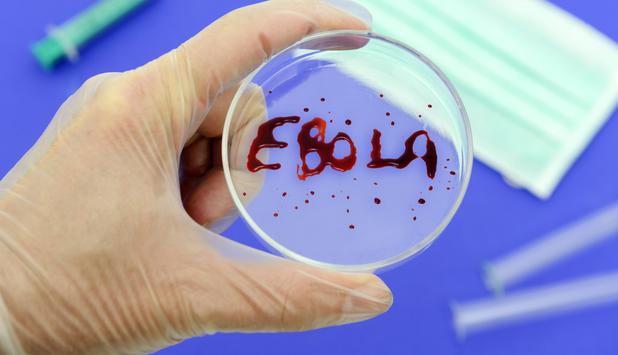

The World Health Organization (WHO) has announced that serum made from the blood of recovered Ebola patients could be available within weeks in Liberia.
Liberia is one of the West African countries worst hit by the Ebola virus.
Speaking in Geneva, Dr. Marie Paule Kieny said work was also advancing quickly to get drugs and a vaccine ready for January 2015.
The Ebola outbreak has already killed more than 4,500 people.
Most of the deaths have been in Guinea, Liberia and Sierra Leone.
Dr, Marie Paule Kieny, WHO assistant director general for health system and innovation, said: “There are partnerships which are starting to be put in place to have capacity in the three countries to safely extract plasma and make preparation that can be used for the treatment of infective patients.
“The partnership which is moving the quickest will be in Liberia where we hope that in the coming weeks there will be facilities set up to collect the blood, treat the blood and be able to process it for use.”
It is still unclear how much will become available and whether it could meet demand.
If a person has successfully fought off the infection, it means their body has learned how to combat the virus and they will have antibodies in their blood that can attack Ebola.
Doctors can then take a sample of their blood and turn it into a treatment called serum – by removing the red blood cells but keeping the important antibodies – for other patients.
Teresa Romero, the Spanish nurse who became the first person to contract Ebola outside West Africa, tested negative for the virus after reportedly receiving human serum containing antibodies from Ebola survivors.
Dr. Marie Paule Kieny said the treatment was not without risks, and WHO has already issued guidelines to ensure safety. Any donor blood will need to be screened for infections such a hepatitis and HIV, for example.
She said trials of two possible Ebola vaccines could produce initial results by the end of the year.
The vaccines will be tested first to see if they are safe for humans, and if they can protect people from the Ebola virus.
Once these questions have been answered, the WHO hopes to extend the trials to a much wider group of people and start giving it to Africa.
“These trials will all start in the coming two weeks… and continue for six months to a year but to have initial results about safety and immunogenicity to have a choice of a dose level by the end of this year in December.”
Dr. Marie Paule Kieny said there were a number of drugs being tested and developed in different countries.
A partnership between Oxford University and the Wellcome Trust is now visiting sites in the three affected African countries to identify which treatment centers would be adequate and willing to start testing drugs soon, she said.
[youtube De-5Fco5RBs 650]
